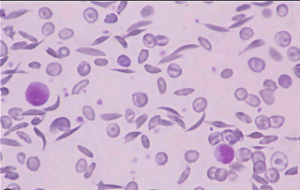

ПАТОГЕННОСТЬ МИКРООРГАНИЗМОВ
1) связана с образованием метаболических ферментов
2) является видовым признаком (+)
3) зависит от факторов окружающей среды
4) проявляется в условиях резистентного организма
УРОВЕНЬ ТЕСТОСТЕРОНА КОЛЕБЛЕТСЯ В ТЕЧЕНИЕ СУТОК, ЕГО МАКСИМАЛЬНЫЙ УРОВЕНЬ НАБЛЮДАЕТСЯ
1) ночью
2) утром (+)
3) вечером
4) днём
ДЛЯ ИССЛЕДОВАНИЯ АКТИВНОСТИ ФЕРМЕНТОВ СЫВОРОТКИ КРОВИ ИСПОЛЬЗУЕТСЯ МЕТОД
1) фотометрии (+)
2) амперометрии
3) кондуктометрии
4) иммуноферментного анализа
К ОБЛИГАТНЫМ ВНУТРИКЛЕТОЧНЫМ ПАРАЗИТАМ ОТНОСЯТСЯ
1) микоплазмы
2) актиномицеты
3) хламидии (+)
4) спирохеты
К ГЕНЕТИЧЕСКИМ РЕКОМБИНАЦИЯМ У БАКТЕРИЙ ОТНОСИТСЯ
1) инверсия
2) конъюгация (+)
3) делеция
4) транслокация
ДЛЯ ПОСТАНОВКИ ДИАГНОЗА «СИСТЕМНЫЙ МИКОЗ» ДОСТАТОЧНО ОБНАРУЖИТЬ ГРИБЫ
1) в волосах
2) на коже
3) на слизистых
4) в крови (+)
ПОДОБНОЕ ИЗМЕНЕНИЕ ФОРМЫ ЭРИТРОЦИТОВ ХАРАКТЕРНО ДЛЯ АНЕМИИ
1) железодефицитной
2) гемолитической
3) беременных
4) серповидно-клеточной (+)
МАКРОЭРГИЧЕСКИМ СОЕДИНЕНИЕМ ЯВЛЯЕТСЯ
1) АТФ (+)
2) жирная кислота
3) глюкоза
4) НАД
ДОНОРСКУЮ КРОВЬ И ЕЕ КОМПОНЕНТЫ, ПРЕДНАЗНАЧЕННЫЕ ДЛЯ ПЕРЕЛИВАНИЯ НОВОРОЖДЕННЫМ, НЕОБХОДИМО ДОПОЛНИТЕЛЬНО ПРОВЕРЯТЬ НА НАЛИЧИЕ
1) Т-лимфотропного вируса человека типа 2 (HTLV-II)
2) вируса гепатита D
3) цитомегаловируса (CMV) (+)
4) вируса Эпштейна-Барр (EBV)
ПАТОГЕННЫЕ ЭШЕРИХИИ ЯВЛЯЮТСЯ
1) сапрофитами
2) возбудителями эшерихиоза (+)
3) внутриклеточными паразитами
4) облигатными патогенами
ЕСТЕСТВЕННЫМ ЗАЩИТНЫМ МЕХАНИЗМОМ ПРИ ПОПАДАНИИ ХОЛЕРНОГО ВИБРИОНА ЧЕРЕЗ РОТ ЯВЛЯЕТСЯ
1) лизоцим тонкого кишечника
2) нормальная кислотность желудка (+)
3) лизоцим
4) желчь
В ОСНОВЕ ИММУНОХИМИЧЕСКИХ МЕТОДОВ ЛЕЖИТ ВЗАИМОДЕЙСТВИЕ
1) антитела с антигеном (+)
2) сыворотки с иммуноглобулином
3) носителя с иммуноглобулином
4) преципитата с субстратом
ОТ ВИТАМИНА К НЕ ЗАВИСИТ
1) фибриноген (+)
2) протромбин
3) проконвертин
4) протеин S
СВЯЗЬ СПЕРМАТОЗОИДА С ЯЙЦЕКЛЕТКОЙ ПРОИСХОДИТ БЛАГОДАРЯ НАЛИЧИЮ У СПЕРМАТОЗОИДА
1) цитоплазматической капли
2) шейки
3) хвоста
4) акросомы (+)
ПЕРИОДИЧНОСТЬ ПРОВЕРКИ ФОТОМЕТРОВ СОСТАВЛЯЕТ
1) 3 года
2) 1 год (+)
3) 6 месяцев
4) 5 лет
КОМПЛЕКС МЕР, НАПРАВЛЕНЫЙ НА ПОЛНОЕ УНИЧТОЖЕНИЕ ВЕГЕТАТИВНЫХ И СПОРОВЫХ ФОРМ МИКРОБОВ В РАЗЛИЧНЫХ МАТЕРИАЛАХ, НАЗЫВАЕТСЯ
1) дезинфекция
2) асептика
3) дезинсекция
4) стерилизация (+)
ВОДНЫМ ПУТЁМ ПЕРЕДАЕТСЯ ВИРУСНЫЙ ГЕПАТИТ
1) A (+)
2) C
3) B
4) D
ПОД ТЕРМИНОМ «ЛЕЙОМИОМА» ПОНИМАЕТСЯ
1) злокачественная опухоль из мышечной ткани
2) доброкачественный неопухолевый процесс
3) доброкачественная опухоль из поперечнополосатой мышечной ткани
4) доброкачественная опухоль из гладкомышечной ткани (+)
ВРЕМЯ СВЁРТЫВАНИЯ ПО ЛИ-УАЙТУ УДЛИНЯЕТСЯ ПРИ
1) гемофилии (+)
2) геморрагическом васкулите
3) тромбастении
4) тромбоцитопении
ПРИ РАКЕ ПРЕДСТАТЕЛЬНОЙ ЖЕЛЕЗЫ ПРЕИМУЩЕСТВЕННО ПОВЫШАЕТСЯ СЫВОРОТОЧНАЯ АКТИВНОСТЬ
1) щелочной фосфатазы
2) кислой фосфатазы (+)
3) альфа-амилазы
4) АЛТ
